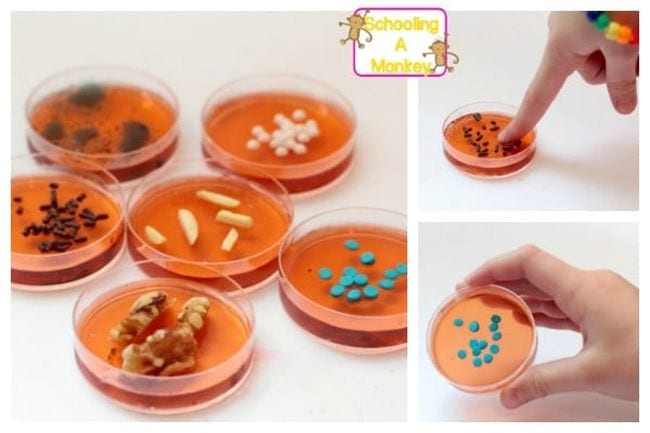

Kitchen and food science are very popular these days, but not every experiment is fit to eat when you’re done. Fortunately, we’ve put together a menu of edible science activities you’ll be happy to snack on! Most of them are easy enough for anyone to tackle and can be completed with items you already have on hand. Bon appétit!
1. DIY Gummy Bears

Students will be so excited to learn how much edible science they can do with one of their favorite candies! First, explore chemical change and protein chains by making your own gummy bears. Then, use the sweet treats for an osmosis experiment.
Learn more: Gummy Bears/Little Bins for Little Hands
2. Layered Lemonade

Use the Fibonacci Sequence to layer different proportions of simple syrup and lemon juice (tinted with food coloring) to create a rainbow-colored drink. The varying densities of the solutions create the layers. Don’t forget to drink the delectable results!
Learn more: Andrea Hawksley
3. Glow In The Dark Jell-O

Add quinine to Jell-O, and you get a totally cool fluorescent snack! Learn about light wavelengths and UV light.
Learn more: Instructables
[contextly_auto_sidebar]
4. Candy Crystals

This is the classic edible science candy experiment! Make a supersaturated sugar solution and then allow it to crystallize around wooden sticks pre-seeded with granulated sugar. The process takes about a week.
Learn more: The Kitchen Pantry Scientist
5. Grape Molecules

We’ve seen this edible science activity done with gumdrops, but we really like the healthy twist of using grapes instead. Use other round fruits for more color.
Learn more: Parties With a Cause
6. Fizzy Lemonade

Mix acidic lemon juice with basic baking soda and watch the chemical reaction, which produces carbonation. Add a little sugar, and students can drink the chemical reaction!
Learn more: Learn with Play at Home
7. Cupcake Core Samples

Kids will feel like real scientists when they use a drinking straw to take a core sample from a cupcake. Bake the cake in layers to represent Earth’s layers to tie this into a geology lesson.
Learn more: 123Homeschool4Me
8. Edible Mars Rover

Learn about the conditions on Mars and the tasks the Mars Rover will need to complete. Then, give kids supplies to build their own. (Add to the challenge by making them “buy” the supplies and stick to a budget, just like NASA!).
Learn more: Library Makers
9. Curds and Whey

Little Miss Muffet sat on her tuffet, eating an edible science experiment! Use the science behind PH, proteins, and colloids to separate milk into curds and whey. Then turn the curds into cheese for a snack.
Learn more: Curds and Whey/Go Science Kids
10. Oreo Moon Phases

Use the chart (click below for the full image in a printable PDF) to create and discuss the different moon phases using Oreo cookies. Of course, you’ll have to eat some of that delicious filling to make some phases!
Learn more: Optics Central
11. Candy DNA Model

Use toothpicks and candy (or fruit, for a healthier option) to build a DNA model. Color code the candies to represent the four chemicals that make up DNA code and snack on them as you discuss the purpose of each.
Learn more: WikiHow
12. Starburst Rock Science

Use Starburst candies to explore the ways pressure and heat form different types of rock. (You’ll need a heat source, like a toaster oven.) Who knew geology could be so sweet?
Learn more: Lemon Lime Adventures
13. Edible Water Bottle

You’ll need some special chemicals, which are readily available online, for this edible science experiment. Follow the directions at the link below to create waste-free water “bottles,” and learn all about spherification.
Learn more: Inhabit
14. Butter Emulsification

Want a delicious way to learn about emulsification? Shake heavy cream in a mason jar until the butter fats separate from the liquids. It’s really that easy—and yummy!
Learn more: Butter Emulsification/Science Buddies
15. Baked Potato Science

This edible science project is a nutritious way to explore the scientific method in action. Experiment with a variety of methods for baking potatoes—microwaving, using a traditional oven, wrapping them in foil, using baking pins, etc.—testing hypotheses to discover which works best.
Learn more: Potato Science/Left Brain Craft Brain
16. Edible Soil Layers

Layer a variety of foods to represent the soil layers, from bedrock on up. If candy doesn’t fit your school’s nutritional guidelines, use fruits, yogurt, granola, and other healthy options. Either way, the results are scrumptious!
Learn more: Super Teacher Blog
17. Jell-O and Enzymes

Make Jell-O using raw pineapple, cooked pineapple, and strawberries to see whether the Jell-O sets properly. (You’ll need a heat source and a refrigerator for this edible science experiment.) Students can eat the results as you talk about the ways different enzymes affect chemical reactions.
Learn more: The Chaos and the Clutter
18. Taste vs. Smell

Have students taste a slice of apple and then again while sniffing a cotton ball soaked in vanilla. Did the smell of vanilla overpower the taste of the apple? Students can finish their apples as you discuss how taste and smell work together.
Learn more: Education.com
19. Edible Cell Model

Use candies or fruits and nuts to represent the different parts of a cell. Kids can nibble as you discuss each item’s purpose and functions. You can also try this with pizza.
Learn more: Lessons With Laughter/Instagram
20. Solar Oven S’mores

This edible science project is a science fair classic! Follow the instructions at the link below to turn a pizza box, aluminum foil, and other basic supplies into a solar-powered oven to cook s’mores or other yummy treats.
Learn more: Desert Chica
21. Sink or Swim Oranges

Place peeled and unpeeled oranges in a container of water to see which ones float and which ones sink. After you discuss the principles of buoyancy, have a healthy snack with your students.
Learn more: Playdough to Plato
22. Jell-O Turbulence

Suspend a (well-cleaned) toy plane in Jell-O (instructions at the link below), then poke and jiggle it to simulate air turbulence. Discuss how layers of air can support a plane, even though you can’t see them.
Learn more: Kids Activities Blog
23. Apple Reactions

Slice an apple and note how it turns brown over time. Experiment with a variety of liquid solutions, including lemon juice, to see which, if any, slow the process. Discuss why or why not, exploring the concept of chemical reactions.
Learn more: Apple Reactions/Teach Beside Me
24. Bread Biology

Bake a simple loaf of bread from scratch, using yeast. Watch the reaction of the yeast with water and sugar, then knead the dough to create the gluten the bread needs to support the rise. (You’ll need an oven to bake the bread to finish this edible science experiment.)
Learn more: Bread Biology/Left Brain Craft Brain
25. Sourdough Science

Yeast makes bread rise, but you don’t have to buy it at the store. Make a sourdough starter using flour and water and watch wild yeast grow and multiply before your eyes. After a week or so, use the sourdough starter to make a savory loaf of bread.
Learn more: King Arthur Flour
26. Sugar Glass

Simulate the way silicon dioxide (sand) is turned into glass but at much more manageable temperatures. Heat sugar until it melts, then cool it to form “glass.” Students can snack on the creation while discussing how amorphous solids are formed.
Learn more: Sugar Glass/Go Science Kids
27. Edible Atoms

Get the free printable worksheet at the link below, then use two colors of mini marshmallows to represent protons and neutrons and chocolate chips for electrons. (Need a healthier option? Try red and green grapes for protons and pumpkin seeds for electrons.)
Learn more: Preschool Powol Packets
28. Cake Reactions

Discover the purpose of various baking ingredients by leaving them out of each recipe. Have students predict what might happen and taste the results! (You’ll need an oven for this edible science experiment.)
Learn more: Cake Reactions/Teach Beside Me
29. Centripetal Force Jell-O

Create test force chambers using a plastic cup, Jell-O, and marbles (get full instructions at the link below). Spin the cup to see how centripetal force moves the marble inside the Jell-O.
Learn more: Centripetal Force Jell-O/Science Buddies
30. Raisin Dehydration

Have students dry grapes in the sun over a period of days to see them turn into raisins! Talk about the process of dehydration as a method of preserving food.
Learn more: Learn Play Imagine
31. Gumdrop Bridges

Use toothpicks and gumdrops to construct a bridge. Test it to see if it will bear weight, then challenge students to build the strongest bridge with the fewest materials. (Let them eat the gumdrops they don’t use!)
Learn more: Little Bins for Little Hands
32. Popcorn Pressure

Calculate the internal pressure needed for popcorn to pop (see the link below for formulas). Then pop the carefully measured corn using the procedure at the link, and check your calculations.
Learn more: Carolina Biological
33. Edible Petri Dishes
Create models in Petri dishes using Jell-O and candies to represent a variety of bacteria, as seen under a microscope. (Get examples at the link below.) Disgustingly delicious!
Learn more: STEAMsational
Love these edible science activities? Here are more Easy Science Experiments Using Materials You Already Have On Hand.
Plus, get all the latest teaching tips and ideas when you sign up for our free newsletters!


